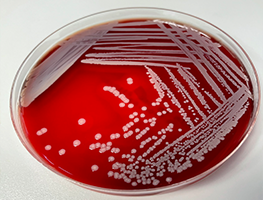
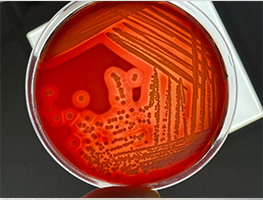

Autogenous Vaccine
- Vaccination is one of the most effective tools in preventing animal diseases and increasing/improving animal health and welfare. It also has an impact on public health by ensuring a safe food supply and preventing infectious diseases transmitted from animals to humans. In addition, vaccination can increase antimicrobial resistance by reducing the use of antibiotics in animals. contributes to the fight against.
- Thanks to vaccines, diseases that cause great losses in animal production have been eliminated and intensive animal production has been made possible. It is necessary to reduce losses; In recent years, national and international organizations have been making priority action plans in order to ensure the timely supply of vaccines in required quantities.
- The process of developing a commercial vaccine and putting it on the market normally takes 5-10 years. Autogenous vaccines (autovaccines) are a complementary tool in veterinary medicine with their rapid production, against new diseases and diseases that do not have a licensed vaccine and are not required to be notified.
- Autogenous vaccines herd; They are custom-made inactivated bacterial and viral vaccines containing specific agents.
- The reasons such as the existence of different subtypes of some bacterial and viral agents, the differences in the distribution of these subtypes by countries or regions, the fact that some diseases are caused by more than one factor, or the time and cost are not suitable to meet the demand. It causes the development of a commercial vaccine against some diseases.
- The use of autogenous vaccines is becoming more and more widespread all over the world, and legal regulations are being established regarding its production and use. "Regulation on Veterinary Medical Products" published in the Official Gazette dated 11.01.2013 and numbered 28525, which includes the changes in the Official Gazette dated 24.12.2011 and numbered 28152 for the production of autogenous vaccines in our country; It is legally regulated by.
- While the production of autogenous vaccines was regulated by different national legislation in each of the European Union countries until recently, the 'Regulation (EU) 2019/6' which came into force in 2022. A joint regulation was adopted with Law No.
- Culture of autogenous vaccines legally in our country in private or public veterinary diagnostic laboratories licensed by the Ministry or in laboratories belonging to the manufacturer; It is allowed to be prepared from microorganisms and to be produced in licensed veterinary medical product production facilities in our country. Autogenous vaccine production is not allowed if there is a licensed vaccine prepared with the same antigenic agents for the same indication in the same animal species.
- Autogenous vaccines ‘Protection/treatment of an animal or animals in the same epidemiological unit or protection/treatment of animals in a unit with proven epidemiological link, derived from pathogen or antigens derived from an animal or animals in an epidemiological unit Inactive immunological veterinary medicinal products used for (Regulation (EU) 2019/6, Article 2. Scope 3).
- Proper selection of bacterial strains constitutes the first stage of autogenous vaccine production, and it is of great importance in terms of the quality, safety and also the desired efficacy of the autogenous vaccine. For this purpose, it is very important to use the correct isolation, identification and typing methods, and these procedures should be carried out in licensed laboratories with competent expertise and infrastructure in these fields.
- Autogenous vaccines can be very effective if they are prepared carefully and duly. &Cedil;∵ It contains all the antigens necessary for protection, belonging to pathogens that cause problems in a herd. herd specific autogenous vaccines mastitis, papillomatosis, respiratory problems etc. It is used in the control of diseases.
- Our laboratory has competent expert personnel and infrastructure for isolation, identification and molecular typing of bacteria, and when requested by enterprises, isolated and identified bacterial cultures are sent to licensed vaccine production facilities and autogenous vaccine The production is provided.

Virtual Tour
Virtual Tour